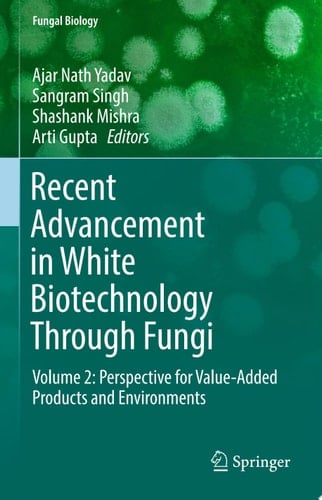
Recent Advancement in White Biotechnology Through Fungi

White biotechnology is industrial biotechnology dealing with various biotech products through applications of microbes. The main application of white biotechnology is commercial production of various useful organic substances, such as acetic acid, citric acid, acetone, glycerine, etc., and antibiotics like penicillin, streptomycin, mitomycin, etc., and value added product through the use of microorganisms especially fungi and bacteria. The value-added products included bioactive compounds, secondary metabolites, pigments and industrially important enzymes for potential applications in agriculture, pharmaceuticals, medicine and allied sectors for human welfare. In the 21st century, techniques were developed to harness fungi to protect human health (through antibiotics, antimicrobial, immunosuppressive agents, value-added products etc.), which led to industrial scale production of enzymes, alkaloids, detergents, acids, biosurfactants. The first large-scale industrial applications of modern biotechnology have been made in the areas of food and animal feed production (agricultural/green biotechnology) and pharmaceuticals (medical/red biotechnology). In contrast, the production of bio-active compounds through fermentation or enzymatic conversion is known industrial or white biotechnology. The beneficial fungal strains may play important role in agriculture, industry and the medical sectors. The beneficial fungi play a significance role in plant growth promotion, and soil fertility using both, direct (solubilization of phosphorus, potassium and zinc; production of indole acetic acid, gibberellic acid, cytokinin and siderophores) and indirect (production of hydrolytic enzymes, siderophores, ammonia, hydrogen cyanides and antibiotics) mechanisms of plant growth promotion for sustainable agriculture. The fungal strains and their products (enzymes, bio-active compounds and secondary metabolites) are very useful for industry. The discovery of antibiotics is a milestone in the
Page Count:
504
Publication Date:
2019-04-24
ISBN-10:
3030148467
ISBN-13:
9783030148461
No comments yet. Be the first to share your thoughts!